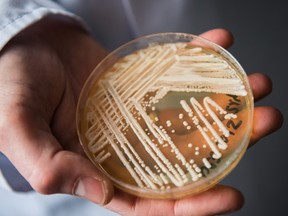

Belagavi:
An elderly couple in Khanapur taluk, Belagavi district, died by suicide after falling victim to cyber fraud and alleged harassment, police said on Friday.
Diogjeron Santan Nazareth (82) and his wife Flaviana (79), residents of Beedi village in Khanapur, had no children, police added.
A two-page handwritten death note left behind by Diogjeron stated their decision to end their lives and requested that no one be blamed, as they did not want to live at the mercy of anyone, police said.
The incident came to light on Thursday when neighbours found Flaviana lifeless on the bed, while Diogjeron’s body was discovered in the underground water tank of their house, they added.
Diogjeron, a retired Maharashtra government secretariat employee, died by stabbing himself in the neck. Injuries were also found on his wrist, police said.
Flaviana is suspected to have consumed poison, though confirmation awaits the autopsy report, they added.
In the death note, Diogjeron named two individuals-Sumit Birra and Anil Yadav. He wrote that Birra, who claimed to be a telecom department official from New Delhi, informed him that a SIM card had been fraudulently purchased in his name and was being used for harassment and illegal advertisements. Birra later transferred the call to Yadav, who claimed to be from the Crime Branch.
Yadav demanded details of Diogjeron’s property and finances, threatening legal consequences over the alleged SIM card misuse, according to the death note, police said.
Falling prey to the scam, Diogjeron transferred over Rs 50 lakh to them, but they continued to demand more, police added, citing digital transaction records.
He also mentioned taking a gold loan of Rs 7.15 lakh, with interest due on June 4.
“The amount should be paid, and the gold should be sold. The amount received after adjusting the principal and interest should be paid to the named persons,” the note read.
Diogjeron further stated that he had borrowed money from friends and requested that the loans be repaid by selling his wife’s gold bangles and earrings.
“Now I am 82 years old, and my wife is 79. We have no one to support us. We do not want to live at the mercy of anyone, so we have taken this decision,” the note said.
He also expressed a wish for their bodies to be donated to a medical institution for students to study.
Police have taken his mobile phone, the knife, and the suicide note into custody as part of the investigation.
“Based on the death note and preliminary inquiry, we have registered a case of abetment to suicide and cyber fraud against the two accused named in the note. Further investigation is underway,” said Belagavi Superintendent of Police Bhimashankar Guled.
(Except for the headline, this story has not been edited by NDTV staff and is published from a syndicated feed.)